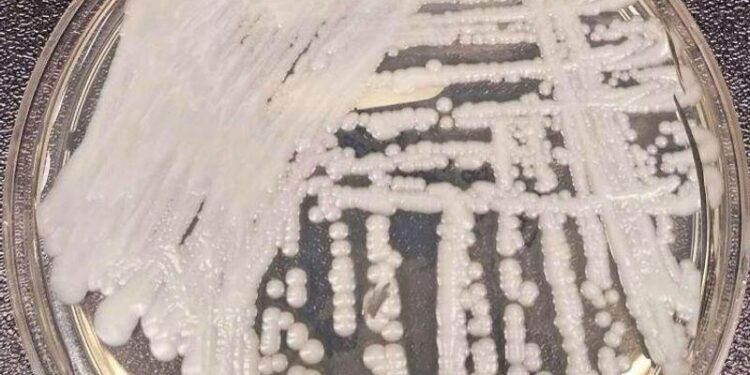
Multidrug-resistant yeast cases rising rapidly in Europe, survey shows – CIDRAP

Escalating Multidrug-Resistant Yeast Infections in Europe: An Urgent Response Required
A troubling rise in multidrug-resistant yeast infections has been reported across Europe,according to a recent analysis by the Center for Infectious Disease Research and Policy (CIDRAP). This alarming trend poses significant challenges for public health systems, which are increasingly struggling to manage infections that are becoming more difficult to treat. The emergence of resistant strains, especially Candida auris, underscores an urgent need for enhanced surveillance and effective infection control measures. Experts warn that without immediate action, the consequences could extend beyond individual health issues, potentially overwhelming healthcare resources and leading to increased mortality rates. As Europe grapples with this escalating threat, the findings raise critical questions about antibiotic management and highlight the necessity of coordinated efforts against antimicrobial resistance.
Critical Need for Surveillance Amid Rising Multidrug-Resistant Yeasts
The increasing incidence of multidrug-resistant yeasts presents a serious public health challenge throughout Europe. Recent studies indicate a significant rise in these drug-resistant organisms within healthcare settings. This concerning situation demands immediate action to monitor and address infections caused by resistant strains such as Candida auris,known for its resistance to multiple antifungal treatments. Health authorities must enhance their surveillance systems to effectively track the emergence and spread of these pathogens.
Inadequate data collection and response strategies exacerbate this issue. Contributing factors include:
- Rising hospital admissions: A growing number of patients with severe underlying conditions require treatment.
- Overuse of antifungal medications: High prescription rates have led to increased resistance among fungal populations.
- Ineffective infection control practices: Many healthcare facilities lack robust protocols for managing outbreaks.
Tackling this emerging crisis necessitates establishing a centralized database that promotes data sharing across regions. Such an initiative would facilitate quicker responses during outbreaks while fostering collaboration among healthcare providers. These efforts will not only enhance patient care but also support ongoing research into new treatment options-ultimately reducing public health risks posed by resilient yeast strains.
Exploring Causes Behind Increased Yeast Infections
The recent survey indicating an increase in multidrug-resistant yeast infections across Europe reveals a complex interplay of factors driving this concerning trend. One major contributor is the overprescription of antibiotics; while they target harmful bacteria, they can also disrupt natural microbial ecosystems-allowing opportunistic fungi like yeasts to flourish unchecked.Additionally, rising numbers of immunocompromised individuals due to conditions such as diabetes or cancer treatments have created larger at-risk populations susceptible to these infections.
- Poor infection control practices within medical facilities;
- The extensive use of invasive devices, including catheters and ventilators;
- Lax hygiene standards strong > among both healthcare workers and patients; li >
The global movement of people enhances opportunities for rapid transmission of resistant yeast strains across borders-rendering geographical barriers less effective at controlling outbreaks. Compounding this issue is a shortage of effective antifungal medications; when standard treatments fail due to growing resistance,pathogens can mutate further-a cycle that perpetuates their resilience against available therapies. Understanding these interconnected factors is crucial as policymakers develop targeted strategies aimed at addressing this escalating public health concern.
Preventive Strategies Against Spread Of Multidrug-Resistant Yeast Infections
The surge in multidrug-resistant yeast infections presents immediate challenges; thus experts emphasize implementing preventive measures within healthcare environments is essential.
Key components include strict adherence to infection control protocols such as:
- Hand Hygiene: strong > Consistent handwashing practices must be rigorously maintained .< / li >
- < strong >Environmental Cleaning:< / strong > Regular disinfection routines should be established especially within high-risk areas.< / li >
- < strong >Antibiotic Stewardship:< / strong > Minimizing unnecessary antibiotic prescriptions can definitely help curb resistance advancement.< / li >
< / ul >< p > Furthermore,< strong > educational initiatives strong > play an essential role ensuring both professionals & patients recognize signs indicating potential infection risks.< br />< br />This includes:< / p >
< ul >
- < strong >Training Workshops:< / strong Frequent sessions should be conducted keeping staff informed about best practices.< / li >
- < strong >Patient Education Materials:< / strong Providing informative resources detailing risk factors & symptoms is vital.< / li >
- < Sophisticated Surveillance Systems:Â Â Implement robust tracking mechanisms capable monitoring trends related both infectious diseases & patterns surrounding antibiotic resistances .< Â / li >
< Â / ul >Final Thoughts on Addressing Rising Threats
This increase in multidrug-resistant yeast infections highlights urgent needs emphasized through CIDRAP’s findings regarding enhanced surveillance alongside improved management techniques . With rising levels observed , it becomes imperative stakeholders collaborate effectively allocating necessary funding towards research endeavors while implementing strategic interventions designed combatting threats posed .As burdens associated continue escalate ,swift adaptations required safeguarding patient welfare preventing further spread . Immediate action needed now ; stakes higher than ever before!